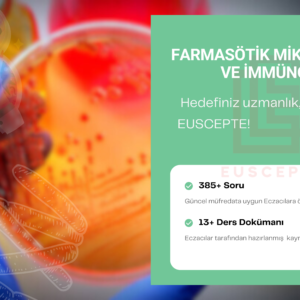

İlginizi çekebilir…
Sepetiniz şu anda boş!
Mağazada yeni
-
İndirimdeki ürün
 Türkiye Geneli Online EUSOrijinal fiyat: ₺350,00.₺200,00Şu andaki fiyat: ₺200,00.
Türkiye Geneli Online EUSOrijinal fiyat: ₺350,00.₺200,00Şu andaki fiyat: ₺200,00. -
İndirimdeki ürün
 BİYOKİMYAOrijinal fiyat: ₺2.150,00.₺1.400,00Şu andaki fiyat: ₺1.400,00.
BİYOKİMYAOrijinal fiyat: ₺2.150,00.₺1.400,00Şu andaki fiyat: ₺1.400,00. -
İndirimdeki ürün
 7’li EUS DenemesiOrijinal fiyat: ₺2.000,00.₺1.400,00Şu andaki fiyat: ₺1.400,00.
7’li EUS DenemesiOrijinal fiyat: ₺2.000,00.₺1.400,00Şu andaki fiyat: ₺1.400,00. -
İndirimdeki ürün
FARMASÖTİK MİKROBİYOLOJİ VE İMMÜNOLOJİOrijinal fiyat: ₺1.550,00.₺1.000,00Şu andaki fiyat: ₺1.000,00.
FARMASÖTİK MİKROBİYOLOJİ VE İMMÜNOLOJİOrijinal fiyat: ₺1.550,00.₺1.000,00Şu andaki fiyat: ₺1.000,00.